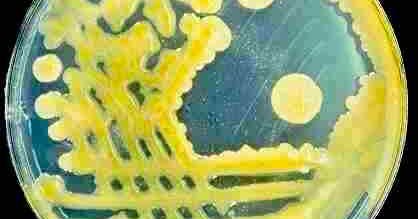
Tweet card summary image

Sofia A. Sánchez
@sofiaasanch
Followers
182
Following
55K
Media
31
Statuses
430
Agricultural Biotechnology Engineer | PhD candidate in Plant Virology 🌽🇦🇷
Joined August 2022
Great energy at the @iabimo poster session! It’s inspiring to see how we keep building knowledge and supporting each other, even when the context for Argentine science is so tough right now. Resilience in action 🇦🇷💪🏻🧬🧪🥼
0
0
2
Espectacular todo lo que aprendimos y discutimos en la 1er agroTalks x WFFArg que realizamos desde el Chapter Argentina. Agradecidos a los invitados de nuestra primera edición ❤️🤞🏼🇦🇷🌽 @World_FoodForum @FAOArgentina
0
0
4
Estoy enferma asique lo unico que hice entre ayer y hoy es ver peliculas, va lista por si quieren ver algo diferente: - Dias de odio (1954) - Fuera de la ley (1937) - Midnight cowboys (1969) - Charade (1963) - The silence of the lambs (1991) - Three colors: red (1994)
0
1
1
The finding that students in environments with long time-to-degree, low faculty-to-student ratios, and very low representation of women experience worse mental health outcomes points to several areas where institutional reforms may be beneficial.
0
0
0
Antiviral reverse transcriptases reveal the evolutionary origin of telomerase
Genome maintenance by telomerase is a fundamental process in nearly all eukaryotes. But where does it come from? Today, we report the discovery of telomerase homologs in a family of antiviral RTs, revealing an unexpected evolutionary origin in bacteria. https://t.co/OlU6HOLQfK
0
28
196
As Nobelist Barry Marshall said when talking about scientific research: “You don’t know where you will end up. You don’t know what you will cure.” @KamounLab
kamounlab.medium.com
I have a special relationship with the bacterium Xanthomonas. As a grad student at UC Davis, I did my thesis research on Xanthomonas…
0
0
0
Aquí no hay prime, siempre que me veas estaré mejor, seré mejor, me irá mejor.
4
7K
17K
A friendly reminder that the Central Dogma is NOT "DNA -> RNA -> protein." All that Francis Crick *actually* said was: “Once information has got into a protein it can’t get out again.” This negative statement — namely, that some transfers of information seem to be impossible —
30
226
1K
Open or closed: ROS-mediated regulation of stomatal movements https://t.co/yHBvIFFSfh
#plantscience
1
24
71
Más 'nuevas olas' de fisiólogos vegetales en la XXXV RAFV!💥💥💥 More 'new waves' of plant physiologists at the XXXV RAFV!💥💥💥 Thanks @jmdambrosio for the photos #RAFV2025
0
6
32
Hermosas 'nuevas olas' de fisiólogos vegetales en la XXXV RAFV🌊🌊🌊 Beautiful 'new waves' of plant physiologists at the XXXV RAFV🌊🌊🌊 Thanks @jmdambrosio for the photos! #RAFV2025
0
11
38
Yesterday, I had the pleasure of presenting part of my PhD project on the P7-1 and P9-2 proteins of the Maize Mal de Río Cuarto virus (MRCV) #RAFV2025 @SocArgFisVeg @iabimo
2
2
33
Para que vayan agendando estas charlas, te dejamos estos datos, dos Carreras Gratuitas de la UNSAM que se dictan en nuestro Instituto, ubicado en Chascomús. En estos encuentros, te brindaremos toda la info sobre estas ofertas académicas. @ebynunsam @unsamoficial
0
10
11
The Guardian also highlights the dramatic situation of science in Argentina. https://t.co/PsflGULZSq
theguardian.com
Javier Milei’s government’s punishing budget cuts have forced researchers to take up work as electricians, school teachers or Uber drivers
0
27
40
El 14 de septiembre de 2015, el espejo tembló. Se movió una trillonésima de metro (10⁻¹⁸ m). Ese temblor, casi imperceptible, fue el primer evento registrado de una onda gravitacional, i.e., la vibración del mismísimo espacio-tiempo: https://t.co/X4AnDiP0j8
3
60
306